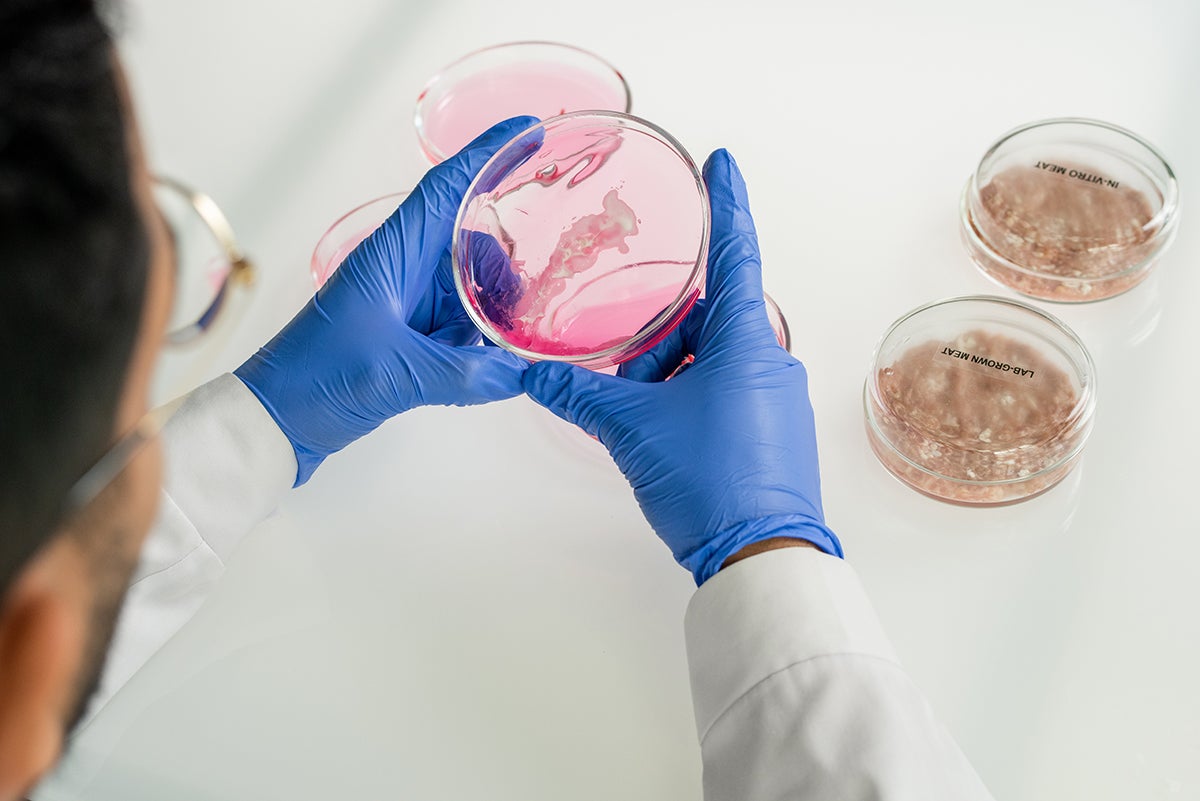
QBRI Insights: The Pursuit of an Effective Anti-Cancer Target
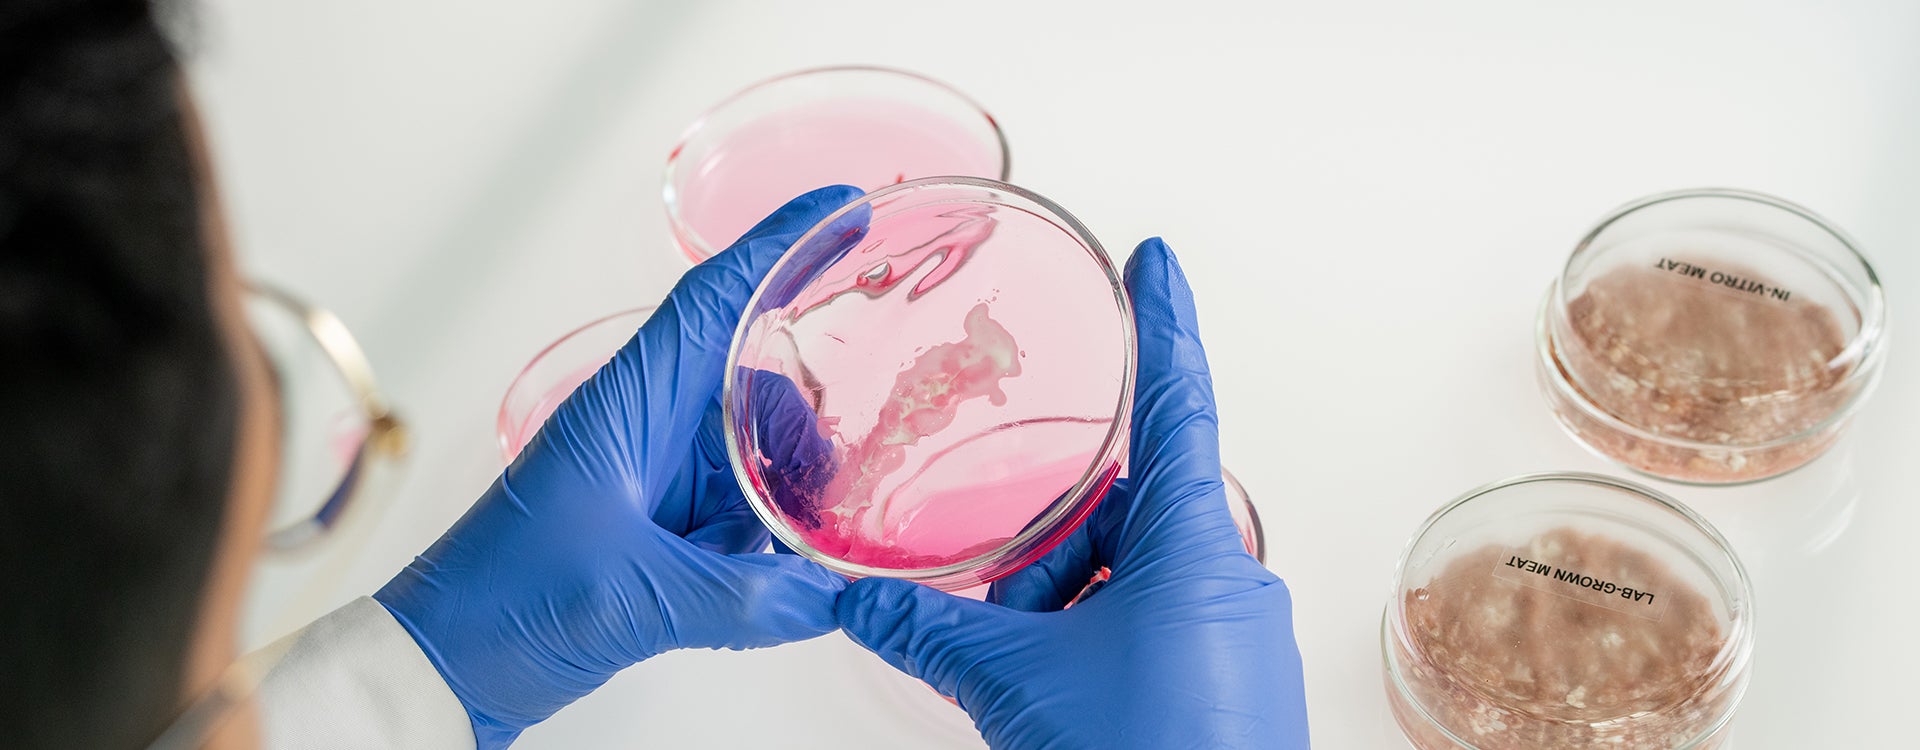

Breast cancer remains the most common cancer in women in Qatar and worldwide, in addition to being the primary cause of female cancer-related death (1). The current gold standard anti-cancer strategies target tumor cells based on characteristics that are more prevalent in these cells (such as high rates of multiplication); however, these properties are not necessarily common to all patients and are often not unique to tumor cells, resulting in variable treatment efficacy among patients and off-target side-effects. Therefore, recent advancements in cancer treatment focus on identifying and targeting highly tumor-specific or unique proteins, with the aim of tailoring each individual’s treatment, also known as personalized or precision medicine.
In this edition, Dr. Adviti Naik, Postdoctoral Researcher in Dr. Julie Decock’s team at the Translational Cancer and Immunity Center (TCIC), Qatar Biomedical Research Institute (QBRI), discusses her recently published work characterizing the role of Lactate Dehydrogenase C (LDHC) in regulating the response of breast tumor cells to DNA damage and the therapeutic potential of targeting this protein to reduce tumor cell survival.
What do we know about LDHC?
A potential anti-cancer target should ideally have restricted expression or be exclusively expressed on tumor cells so that targeting the molecule does not adversely affect normal cells. In addition, this protein should also play a role in driving tumor survival and progression, so that the target-specific intervention can inhibit tumor growth. In the search for novel candidate targets, Dr. Decock’s group is particularly interested in a group of proteins known as Cancer Testis Antigens (CTAs) (consisting of over 700 proteins). Expression of CTAs in normal tissues is predominantly restricted to adult testis cells with no or very low expression in other normal adult human tissues, whereas they are often re-expressed in tumors (2). Moreover, recent evidence has indicated numerous roles of CTAs in promoting tumor development and progression, and their expression has been associated with advanced disease and poorer survival rates.
Lactate Dehydrogenase C (LDHC) is a CTA that was initially discovered as a regulator of male fertility, given its role in sperm metabolism and motility (3). In our recent publication (4), we reported that LDHC is highly expressed in breast tumors, particularly in a tumor type known as basal-like breast cancer that is associated with poor clinical outcomes (5). Furthermore, we observed that higher expression of LDHC correlated with lower survival rates. As the role of LDHC in cancer is not well studied, we decided to address this knowledge gap in breast cancer. Given the highly tumor-specific expression of LDHC, we also explored whether targeting LDHC could affect breast tumor cell survival.
Targeting LDHC in Breast Tumor Cells
Using laboratory techniques, we reduced or “silenced” the expression of LDHC in four breast tumor cell lines and studied various properties of these cells. We observed that cells with reduced LDHC expression displayed increased damage to the DNA (the genetic code of a cell) and distinct abnormalities in cell division. In normal cells, cell division is a highly regulated process to ensure that cells do not multiply under unfavorable conditions, such as when their DNA is damaged or the amount of genetic information has been altered. As cells undergo cell division, they pass through a series of stages, controlled by checkpoints, which is collectively known as the cell cycle. However, tumor cells have the ability to hijack these checkpoints and undergo uncontrolled cell division and multiplication.
Through in-depth analysis of the cell cycle, we have shown that reducing LDHC expression shortens the duration of the cell cycle by overriding the cell cycle checkpoints, thus resulting in cells with abnormal and damaged DNA. While low levels of compromised DNA integrity promote tumor cell survival by introducing DNA mutations/alterations that can provide a survival and growth advantage for the cell, excessive levels can drive tumor cells towards cell death. Indeed, we found that the increased DNA damage and abnormalities resulting from reduced LDHC expression were poorly tolerated, consequently decreasing tumor cell survival.
Clinical Implications
Certain breast cancer subtypes are inherently known to have defects in repairing DNA damage, leading to the accumulation of DNA abnormalities that promote further tumor growth and progression. For instance, breast tumors with inherited mutations in the breast cancer susceptibility genes BRCA1/2 have characteristic abnormalities in DNA repair. According to current treatment recommendations, breast cancer patients with BRCA1/2 mutations can be treated with drugs that either induce excessive DNA damage (such as platinum-based chemotherapy) or that further block DNA damage repair (such as inhibitors that block the activity of PARP, a protein involved in the DNA damage response), leading to intolerable levels of DNA abnormalities and tumor cell death. However, BRCA mutant patients who can benefit from these treatments account for only a small proportion of breast cancer patients (10%) (6). Since we observed defective DNA damage repair in our breast tumor cell lines with reduced LDHC expression but without BRCA1/2 mutations, we were interested to see if targeting LDHC could make the breast tumor cells more sensitive to DNA damage repair therapies.
As anticipated, treatment with a DNA damaging drug, cisplatin, or with a drug inhibiting DNA damage repair, olaparib, significantly increased DNA damage in breast tumor cells with reduced LDHC, and further reduced tumor cell survival. This observation is particularly promising as it suggests that targeting LDHC could improve the clinical outcome of LDHC-expressing breast tumors not only through direct interference with the role of LDHC in tumor cells but also by providing a way to benefit from treatment with DNA damage response targeted therapy in the absence of BRCA1/2 mutations.
In summary, the targeting of LDHC in breast tumor cells has the potential to tip the fine balance between tolerable and excessive levels of DNA damage in favor of the latter to reduce tumor cell survival and as such to sensitize tumor cells to DNA damage response targeted therapy. Future work will involve confirming these findings in mouse models and developing LDHC-specific therapeutic interventions using specific chemical inhibitors or approaches to deliver molecules to reduce LDHC in tumors.
The current work, authored by Dr. Naik and Dr. Decock, was published in the Molecular Oncology journal (FEBS Press) under the title “Targeting of lactate dehydrogenase C dysregulates the cell cycle and sensitizes breast tumor cells to DNA damage response targeted therapy”.

Figure 1. Targeting the cancer-testis antigen LDHC in breast cancer to reduce tumor cell survival and improve sensitivity to DNA damage response targeted therapy.
Contribution and illustration by: Dr. Adviti Naik (Postdoctoral Researcher, QBRI)
Editors: Dr. Prasanna Kolatkar (Senior Scientist, QBRI), Dr. Julie Decock (Scientist, QBRI)
Arabic text validation: Rowaida Ziad Taha (Research Associate, QBRI)
References
- Sung H, Ferlay J, Siegel RL, Laversanne M, Soerjomataram I, Jemal A, et al. Global Cancer Statistics 2020: GLOBOCAN Estimates of Incidence and Mortality Worldwide for 36 Cancers in 185 Countries. CA: A Cancer Journal for Clinicians. 2021;71(3):209-49.
- Gjerstorff MF, Andersen MH, Ditzel HJ. Oncogenic cancer/testis antigens: prime candidates for immunotherapy. Oncotarget. 2015;6(18):15772-87.
- Goldberg E, Eddy EM, Duan C, Odet F. LDHC: the ultimate testis-specific gene. Journal of Andrology. 2010;31(1):86-94.
- Naik A, Decock J. Targeting of lactate dehydrogenase C dysregulates the cell cycle and sensitizes breast cancer cells to DNA damage response targeted therapy. Molecular Oncology. 2021.
- Caan BJ, Sweeney C, Habel LA, Kwan ML, Kroenke CH, Weltzien EK, et al. Intrinsic subtypes from the PAM50 gene expression assay in a population-based breast cancer survivor cohort: prognostication of short- and long-term outcomes. Cancer Epidemiology, Biomarkers & Prevention: a publication of the American Association for Cancer Research, cosponsored by the American Society of Preventive Oncology. 2014;23(5):725-34.
- Armstrong N, Ryder S, Forbes C, Ross J, Quek RG. A systematic review of the international prevalence of BRCA mutation in breast cancer. Clinical Epidemiology. 2019; 11:543-61.
Related News